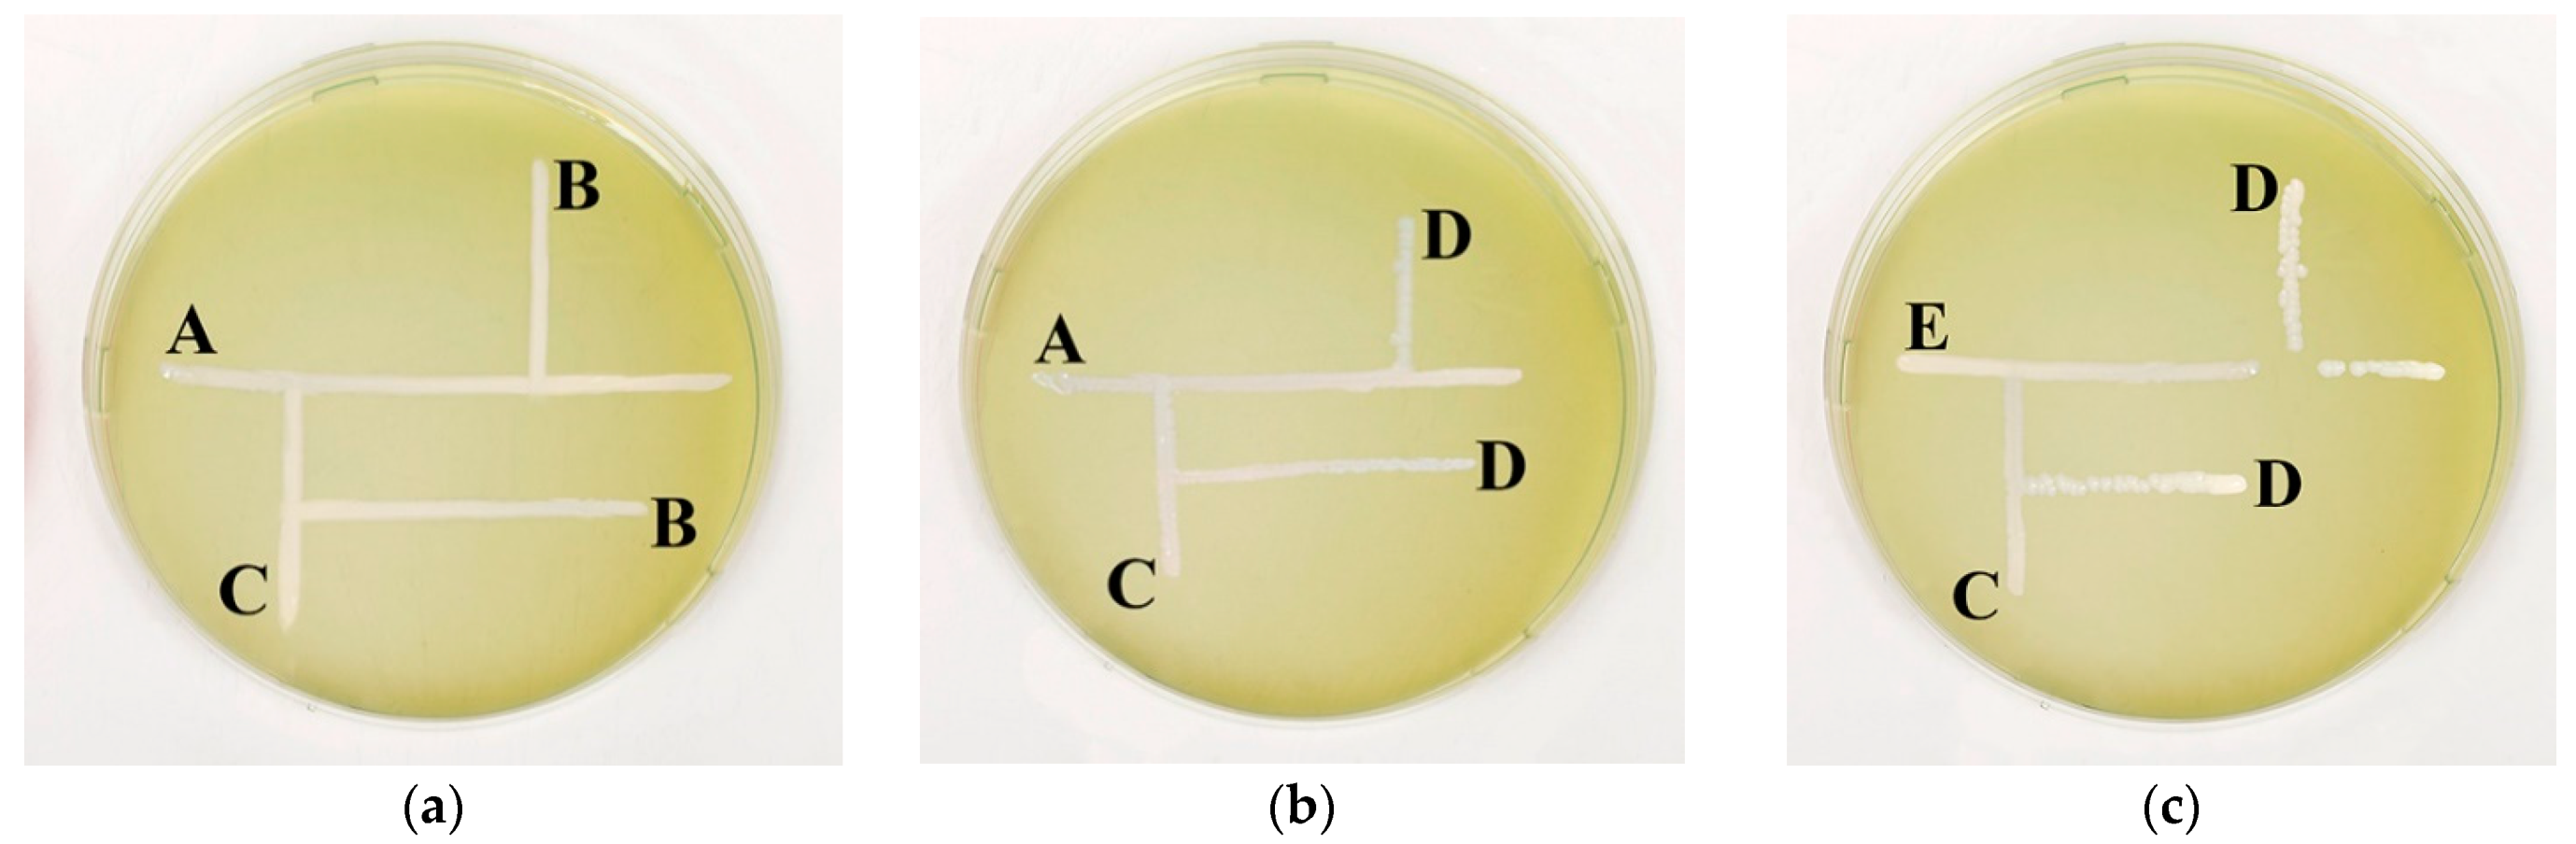
Agriculture 13 01534 g001

Development of a Lactic Bacteria Starter for Amaranth Silage and Investigation of Its Influence on Silage Quality
Abstract
1. Introduction
2. Materials and Methods
2.1. Lactic Acid Bacteria Screening
2.2. Cultivation of Strains of Lactic Acid Bacteria
2.3. Silo Preparation
2.4. Study of Microflora and pH during Amaranth Ensiling
2.5. Determination of Quality Indicators of Amaranth Silage
2.6. Statistical Analysis
3. Results and Discussion
3.1. Development of a Silage Starter for Amaranth Ensiling
3.2. Study of the Microflora of Amaranth during Ensiling
3.3. Influence of the Composition of Starter Cultures on the Quality of Amaranth Silage
4. Conclusions
Author Contributions
Funding
Institutional Review Board Statement
Data Availability Statement
Conflicts of Interest
References
- Pavlenkova, S.V.; Shuveva, G.P.; Mescheryakova, O.L.; Miroshnichenko, L.A.; Korneeva, O.S. Amaranth—A promising crop for fodder manufacturing. J. Biotechnol. 2017, 256, S27. [Google Scholar] [CrossRef]
- Nogoy, K.M.C.; Yu, J.; Song, Y.G.; Li, S.; Chung, J.-W.; Choi, S.H. Evaluation of the Nutrient Composition, In Vitro Fermentation Characteristics, and In Situ Degradability of Amaranthus caudatus, Amaranthus cruentus, and Amaranthus hypochondriacus in Cattle. Animals 2021, 11, 18. [Google Scholar] [CrossRef] [PubMed]
- Gresta, F.; Meineri, G.; Oteri, M.; Santonoceto, C.; Lo Presti, V.; Costale, A.; Chiofalo, B. Productive and Qualitative Traits of Amaranthus Cruentus L.: An Unconventional Healthy Ingredient in Animal Feed. Animals 2020, 10, 1428. [Google Scholar] [CrossRef]
- Ma, J.; Sun, G.; Shah, A.M.; Fan, X.; Li, S.; Yu, X. Effects of Different Growth Stages of Amaranth Silage on the Rumen Degradation of Dairy Cows. Animals 2019, 9, 793. [Google Scholar] [CrossRef]
- Rezaei, J.; Rouzbehan, Y.; Fazaeli, H. Nutritive value of fresh and ensiled amaranth (Amaranthushy pochondriacus) treated with different levels of molasses. Anim. Feed Sci. Technol. 2009, 151, 153–160. [Google Scholar] [CrossRef]
- Abbasi, D.; Rouzbehan, Y.; Rezaei, J. Effect of harvest date and nitrogen fertilization rate on the nutritive value of amaranth forage (Amaranthushy pochondriacus). Anim. Feed Sci. Technol. 2012, 171, 6–13. [Google Scholar] [CrossRef]
- Hosseini, S.A.; Rouzbehan, Y.; Fazaeli, H.; Rezaei, J. Comparing the yield and nutritional value of ensiled amaranth (Amaranthushy pochondriacus) cultivars with corn silage (Zea mays) in doublecropping condition. Transl. Anim. Sci. 2023, 7, txac158. [Google Scholar] [CrossRef]
- Aguilar, E.G.; Peiretti, E.G.; Uñates, M.A.; Marchevsky, E.J.; Escudero, N.L.; Camiña, J.M. Amaranth seed varieties: A chemometric approach. Food Meas. 2013, 7, 199–206. [Google Scholar] [CrossRef]
- Awasthi, C.P.; Kumar, A.; Singh, N.; Thakur, R. Biochemical composition of grain amaranth genotypes of himachalpradesh. Indian J. Agric. Biochem. 2011, 24, 141–144. [Google Scholar]
- Baraniak, J.; Kania-Dobrowolska, M. The Dual Nature of Amaranth—Functional Food and Potential Medicine. Foods 2022, 11, 618. [Google Scholar] [CrossRef]
- Vysochina, G.I. Amaranth (Amaranthus L.): Chemical composition and prospects of use (review). Chem. Plant Raw Mater. 2013, 2, 5–14. (In Russian) [Google Scholar] [CrossRef]
- Lima, R.; Lourenco, M.; Diaz, R.; Castro, A.; Fievez, V. Effect of combined ensiling of sorghum and soybean with or without molasses and Lactobacilli on silage quality and in vitro rumen fermentation. Anim. Feed Sci. Technol. 2010, 155, 122–131. [Google Scholar] [CrossRef]
- Reich, L.J.; Kung, L., Jr. Effects of combining Lactobacillus buchneri40788 with various lactic acid bacteria on the fermentation and aerobic stability ofcorn silage. Anim. Feed Sci. Technol. 2010, 159, 105–109. [Google Scholar] [CrossRef]
- Nair, J.; Xu, S.; Smiley, B.; Yang, H.-E.; McAllister, T.A.; Wang, Y. Effects of inoculation of corn silage with Lactobacillus spp. or Saccharomyces cerevisiae alone or in combination on silage fermentation characteristics, nutrient digestibility, and growth performance of growing beef cattle. J. Anim. Sci. 2019, 97, 4974–4986. [Google Scholar] [CrossRef]
- Paradhipta, D.H.V.; Lee, S.S.; Kang, B.; Joo, Y.H.; Lee, H.J.; Lee, Y.; Kim, J.; Kim, S.C. Dual-Purpose Inoculants and Their Effects on Corn Silage. Microorganisms 2020, 8, 765. [Google Scholar] [CrossRef]
- Wu, Z.; Xu, S.; Yun, Y.; Jia, T.; Yu, Z. Effect of 3-Phenyllactic Acid and 3-Phenyllactic Acid-Producing Lactic Acid Bacteria on the Characteristics of Alfalfa Silage. Agriculture 2020, 10, 10. [Google Scholar] [CrossRef]
- Su, R.; Ni, K.; Wang, T.; Yang, X.; Zhang, J.; Liu, Y.; Shi, W.; Yan, L.; Jie, C.; Zhong, J. Effects of ferulic acid esterase-producing Lactobacillus fermentum and cellulose additives on the fermentation quality and microbial community of alfalfa silage. PeerJ 2019, 7, e7712. [Google Scholar] [CrossRef]
- Yang, L.; Yuan, X.; Li, J.; Dong, Z.; Shao, T. Dynamics of microbial community and fermentation quality during ensiling of sterile and nonsterile alfalfa with or without Lactobacillus plantarum inoculant. Bioresour. Technol. 2019, 275, 280–287. [Google Scholar] [CrossRef]
- Abbasi, M.; Rouzbehan, Y.; Rezaei, J.; Jacobsen, S.-E. The effect of lactic acid bacteria inoculation, molasses, or wilting on the fermentation quality and nutritive value of amaranth (Amaranthushy pochondriacus) silage. J. Anim. Sci. 2018, 96, 3983–3992. [Google Scholar] [CrossRef]
- Zhao, M.; Wang, Z.; Du, S.; Sun, L.; Bao, J.; Hao, J.; Ge, G. Lactobacillus plantarum and propionic acid improve the fermentation quality of high-moisture amaranth silage by altering the microbial community composition. Front. Microbiol. 2022, 13, 1066641. [Google Scholar] [CrossRef]
- Mu, L.; Xie, Z.; Hu, L.; Chen, G.; Zhang, Z. Lactobacillus plantarum and molasses alter dynamic chemical composition, microbial community, and aerobic stability of mixed (amaranth and rice straw) silage. J. Sci. Food Agric. 2021, 101, 5225–5235. [Google Scholar] [CrossRef] [PubMed]
- Kablova, M.A.; Shurkhno, R.A.; Sirotkin, A.S. Lactic acid bacteria in agricultural production. Bull. Technol. Univ. 2015, 18, 145–149. (In Russian) [Google Scholar]
- Irkitova, A.N.; Kagan, Y.R.; Sokolova, G.G. Comparative analysis of methods for determining the antagonistic activity of lactic acid bacteria. Bull. Altai State Univ. 2012, 3, 41–44. (In Russian) [Google Scholar]
- Petukhova, E.A.; Bessarabova, R.F.; Khalenova, L.D. Zootechnical Analysis of Feed; Agropromizdat: Moscow, Russia, 1989. [Google Scholar]
- Sarıçiçek, B.Z.; Yıldırım, B.; Kocabaş, Z.; Demir, E.O. Effect of Storage Time on Nutrient Composition and Quality Parameters of Corn Silage. Turk. J. Agric.-Food Sci. Technol. 2016, 4, 934–939. [Google Scholar] [CrossRef]
- Sanzheev, A.P.; Mikhina, A.A.; Sevko, D.A.; Sevko, A.V.; Vorozheykin, S.V.; Anokhina, E.P.; Korotaeva, A.A. Existing problems and ways of their solution in the analysis of amino acid composition. Vestn. VGUIT Proc. VSUET 2018, 80, 185–189. (In Russian) [Google Scholar] [CrossRef]
- Yitbarek, M.B.; Tamir, B. Silage Additives: Review. Open J. Appl. Sci. 2014, 4, 258–274. [Google Scholar] [CrossRef]
- Cai, Y.; Yang, J.; Pang, H.; Kitahara, M. Lactococcus fujiensis sp. nov., a lactic acid bacterium isolated from vegetable matter. Int. J. Syst. Evol. Microbiol. 2011, 61, 1590–1594. [Google Scholar] [CrossRef][Green Version]
- Liu, Q.H.; Yang, F.Y.; Zhang, J.G.; Shao, T. Characteristics of Lactobacillus parafarraginis ZH1 and its role in improving the aerobic stability of silages. J. Appl. Microbiol. 2014, 117, 405–416. [Google Scholar] [CrossRef]
- Liu, Q.; Lindow, S.E.; Zhang, J. Lactobacillus parafarraginis ZH1 producing anti-yeast substances to improve the aerobic stability of silage. Anim. Sci. J. 2018, 89, 1302–1309. [Google Scholar] [CrossRef]
- Stoyanova, L.G.; Ustyugova, E.A.; Netrusov, A.I. Antimicrobial metabolites of lactic acid bacteria: Diversity and properties (review). Appl. Biochem. Microbiol. 2012, 48, 259–275. (In Russian) [Google Scholar] [CrossRef]
- Muck, R.E. Silage microbiology and its control through additives. Rev. Bras. Zootec. 2010, 39, 183–191. [Google Scholar] [CrossRef]
- Jia, T.; Yun, Y.; Yu, Z. Propionic acid and sodium benzoate affected biogenic amine formation, microbial community, and quality of oat silage. Front. Microbiol. 2021, 12, 750920. [Google Scholar] [CrossRef] [PubMed]

| Lactic Acid Bacteria Strain | Decrease in Optic Density of Test-Culture Suspension, % | |
|---|---|---|
| Staphylococcus aureus | Escherichia coli | |
| Lactobacillus plantarum B-10816 | 49 | 37 |
| Enterococcus hirae B-9069 | 27 | 14 |
| Lactobacillus fermentum B-10888 | 35 | 50 |
| Lactococcus lactis subsp. lactis B-6793 | 44 | 32 |
| Lactococcus lactis subsp. cremoris B-3873 | 8 | 30 |
| Lactococcus lactis subsp. lactis var diacetylactis B-5600 | 29 | 44 |
| Leuconostoc mesenteroides subsp. dextranicum B-3425 | 34 | 45 |
| Streptococcus thermophiles B-4463 | 29 | 0 |
| Consotium Variant No. | Starter Cultures Variants |
|---|---|
| MPF | Leuc. mesenteroides susp. dextranicum B-3425; L. plantarum B-10816; L. fermentum B-10888 |
| MLF | Leuc. mesenteroides susp. dextranicum B-3425; Lac. lactis subsp. lactis B-6793; L. fermentum B-10888 |
| LLF | Lac. lactis subsp. lactis var diacetylactis B-5600; Lac. lactis subsp. lactis B-6793; L. fermentum B-10888 |
| Organic Acid | Mass Fraction of the Total Acid Content, % | SEM | p-Value | |||
|---|---|---|---|---|---|---|
| Starter | ||||||
| MPF | MLF | Baktosil | Without Treatment | |||
| Lactic acid | 75.1 ± 0.8 a | 65.4 ± 0.7 b | 57.6 ± 0.8 c | 29.1 ± 0.8 d | 0.3 | <0.0002 |
| Acetic acid | 24.9 ± 0.6 d | 34.5 ± 0.6 c | 42.2 ± 0.7 b | 70.3 ± 0.6 a | 0.2 | <0.0002 |
| Butyric acid | 0 | 0.1 ± 0.08 c | 0.2 ± 0.07 b | 0.6 ± 0.07 a | 0.03 | <0.0476 |
| Indicators | Raw Material | Amaranth Silage | Corn Silage | SEM | p-Value | |||
|---|---|---|---|---|---|---|---|---|
| Starters | ||||||||
| MPF | MLF | Baktosil | Without Treatment | |||||
| Crude protein, % | 15.5 ± 0.2 a | 13.9 ± 0.3 b | 10.4 ± 0.3 c | 8.1 ± 0.2 d | 6.3 ± 0.3 e | 6.3 ± 0.2 e | 0.14 | <0.0002 |
| Crude fat, % | 4.3 ± 0.3 a | 4.0 ± 0.2 a | 3.6 ± 0.3 b | 3.3 ± 0.3 b | 2.9 ± 0.4 b | 0.9 ± 0.3 c | 0.18 | <0.0270 |
| Crude fiber, % | 21.3 ± 0.4 a | 20.4 ± 0.2 a | 21.1 ± 0.4 a | 20.8 ± 0.4 a | 20.7 ± 0.2 a | 23.6 ± 0.4 b | 0.17 | <0.0002 |
| Carotene, mg/kg | 24.9 ± 0.3 a | 24.1 ± 0.3 b | 22.9 ± 0.2 c | 21.8 ± 0.3 d | 20.1 ± 0.2 e | 19.3 ± 0.4 f | 0.15 | <0.0026 |
| No. | Amino Acids | Mass Rate in Silage, % | |
|---|---|---|---|
| Amaranth Silage | Corn Silage | ||
| 1 | valine | 0.73 | 0.37 |
| 2 | methonine | 0.11 | 0.09 |
| 3 | isoleucine | 0.61 | 0.26 |
| 4 | leucine | 0.97 | 0.70 |
| 5 | phenylalanine | 0.63 | 0.30 |
| 6 | lysine | 0.72 | 0.27 |
| 7 | threonine | 0.54 | 0.26 |
| 8 | tryptophan | 0.09 | 0.04 |
| Sum of essential amino acids | 4.40 | 2.32 | |
Disclaimer/Publisher’s Note: The statements, opinions and data contained in all publications are solely those of the individual author(s) and contributor(s) and not of MDPI and/or the editor(s). MDPI and/or the editor(s) disclaim responsibility for any injury to people or property resulting from any ideas, methods, instructions or products referred to in the content. |
© 2023 by the authors. Licensee MDPI, Basel, Switzerland. This article is an open access article distributed under the terms and conditions of the Creative Commons Attribution (CC BY) license (https://creativecommons.org/licenses/by/4.0/).
Share and Cite
Anokhina, E.; Obraztsova, S.; Tolkacheva, A.; Cherenkov, D.; Sviridova, T.; Korneeva, O. Development of a Lactic Bacteria Starter for Amaranth Silage and Investigation of Its Influence on Silage Quality. Agriculture 2023, 13, 1534. https://doi.org/10.3390/agriculture13081534
Anokhina E, Obraztsova S, Tolkacheva A, Cherenkov D, Sviridova T, Korneeva O. Development of a Lactic Bacteria Starter for Amaranth Silage and Investigation of Its Influence on Silage Quality. Agriculture. 2023; 13(8):1534. https://doi.org/10.3390/agriculture13081534
Chicago/Turabian StyleAnokhina, Ekaterina, Svetlana Obraztsova, Anna Tolkacheva, Dmitrii Cherenkov, Tatyana Sviridova, and Olga Korneeva. 2023. "Development of a Lactic Bacteria Starter for Amaranth Silage and Investigation of Its Influence on Silage Quality" Agriculture 13, no. 8: 1534. https://doi.org/10.3390/agriculture13081534
APA StyleAnokhina, E., Obraztsova, S., Tolkacheva, A., Cherenkov, D., Sviridova, T., & Korneeva, O. (2023). Development of a Lactic Bacteria Starter for Amaranth Silage and Investigation of Its Influence on Silage Quality. Agriculture, 13(8), 1534. https://doi.org/10.3390/agriculture13081534

